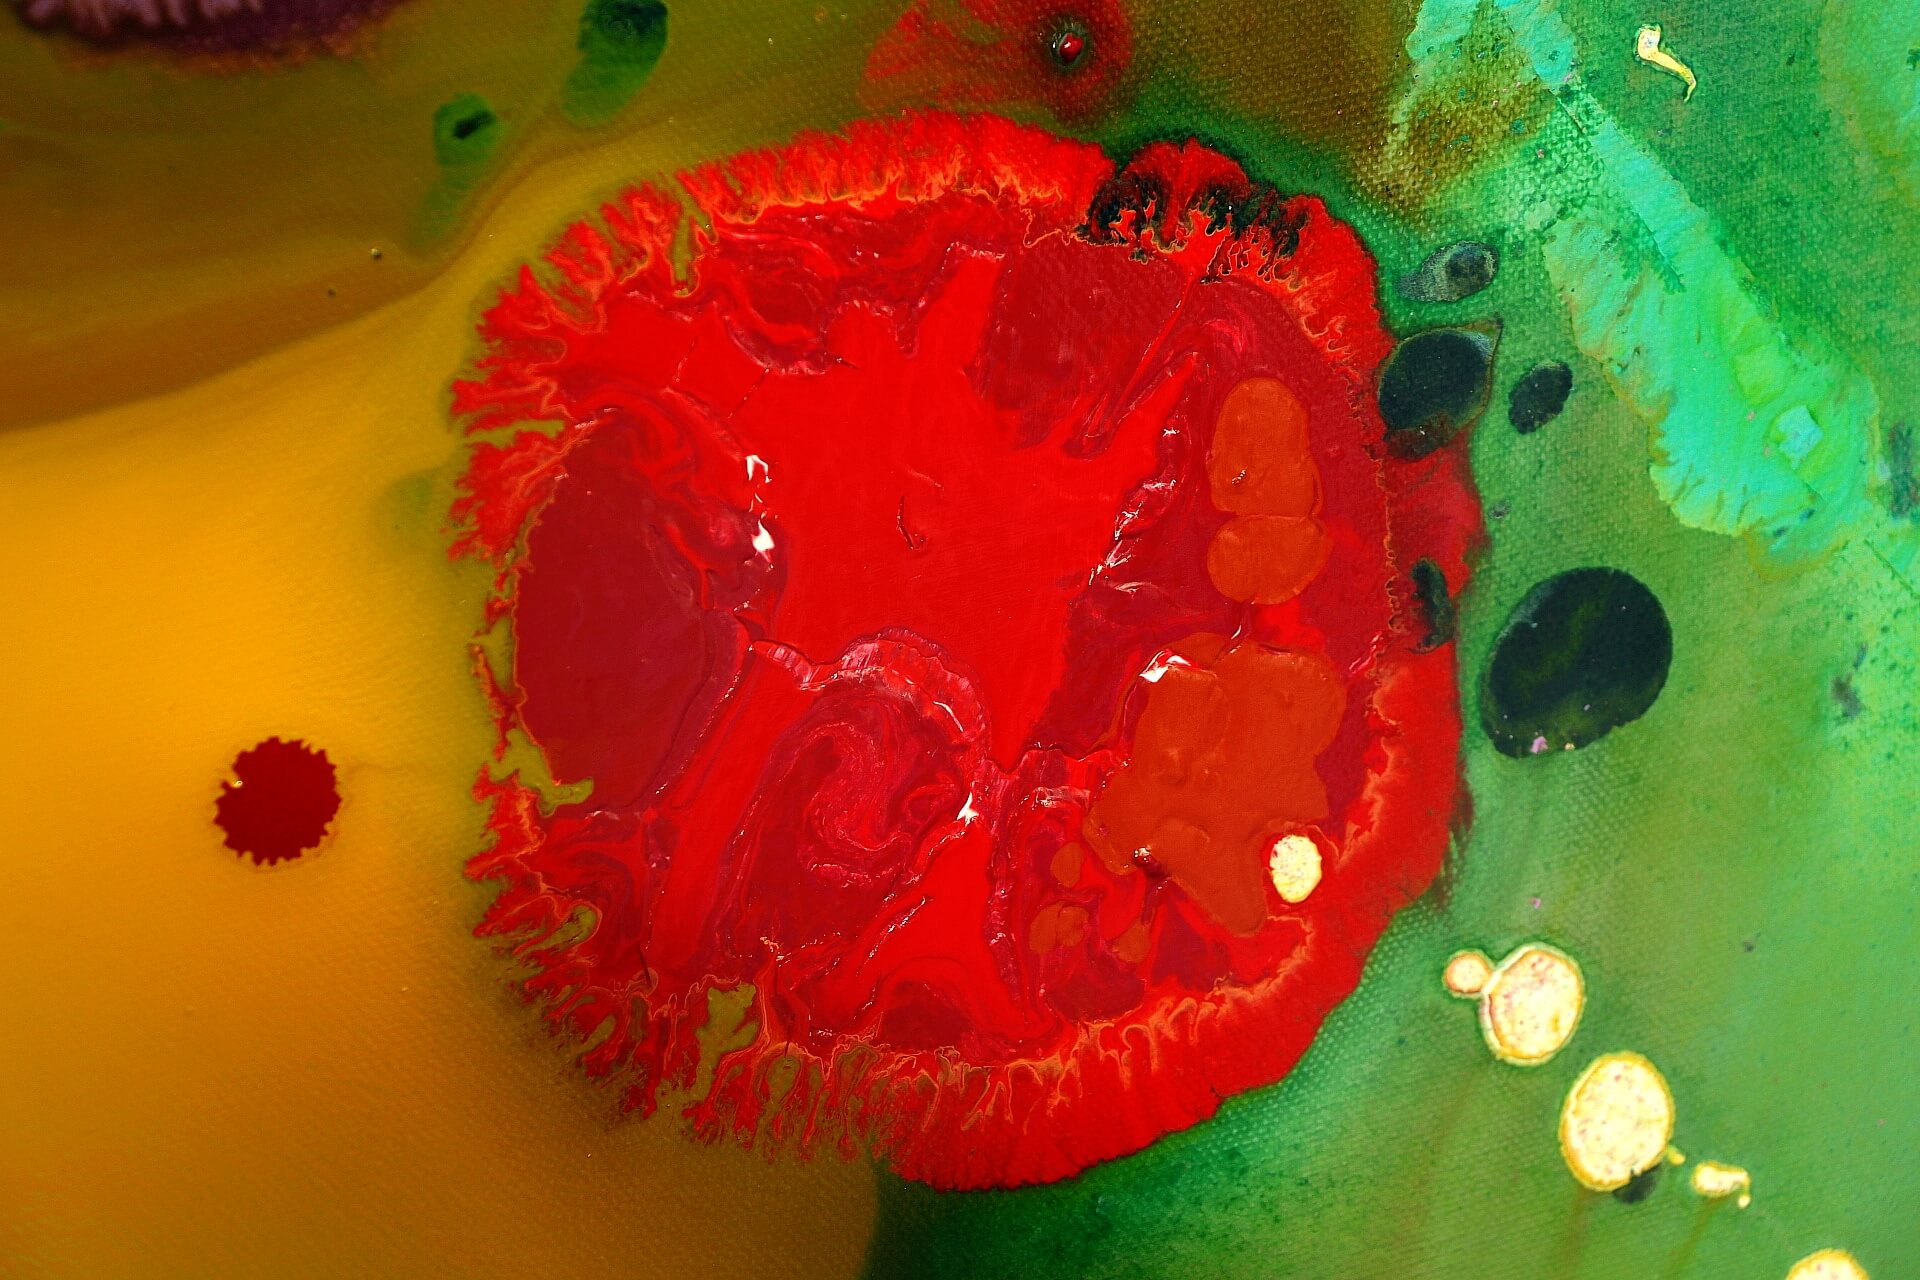

LIMEN designates the space of transition – that narrow field between perception and dissolution, where form and meaning begin to shimmer. The works revolve around the threshold as a condition, a fragile zone in which opposites can no longer be separated: light and shadow, inside and outside, being and vanishing.

The surface of the paintings appears taut – a delicate skin, traversed by fissures, glazes, and pulsating lines. Here, matter opens, becomes transparent, allowing the invisible to shine through. Color loses its solidity, becoming breath, becoming movement.
In LIMEN, a state of suspension unfolds: the visible dissolves, the invisible condenses. What remains is the experience of a boundary that transcends itself – a state of pure possibility, a moment between emergence and withdrawal.
To learn more about this work, please call us at +49 221 9982817 or leave your contact information. We will get back to you shortly.